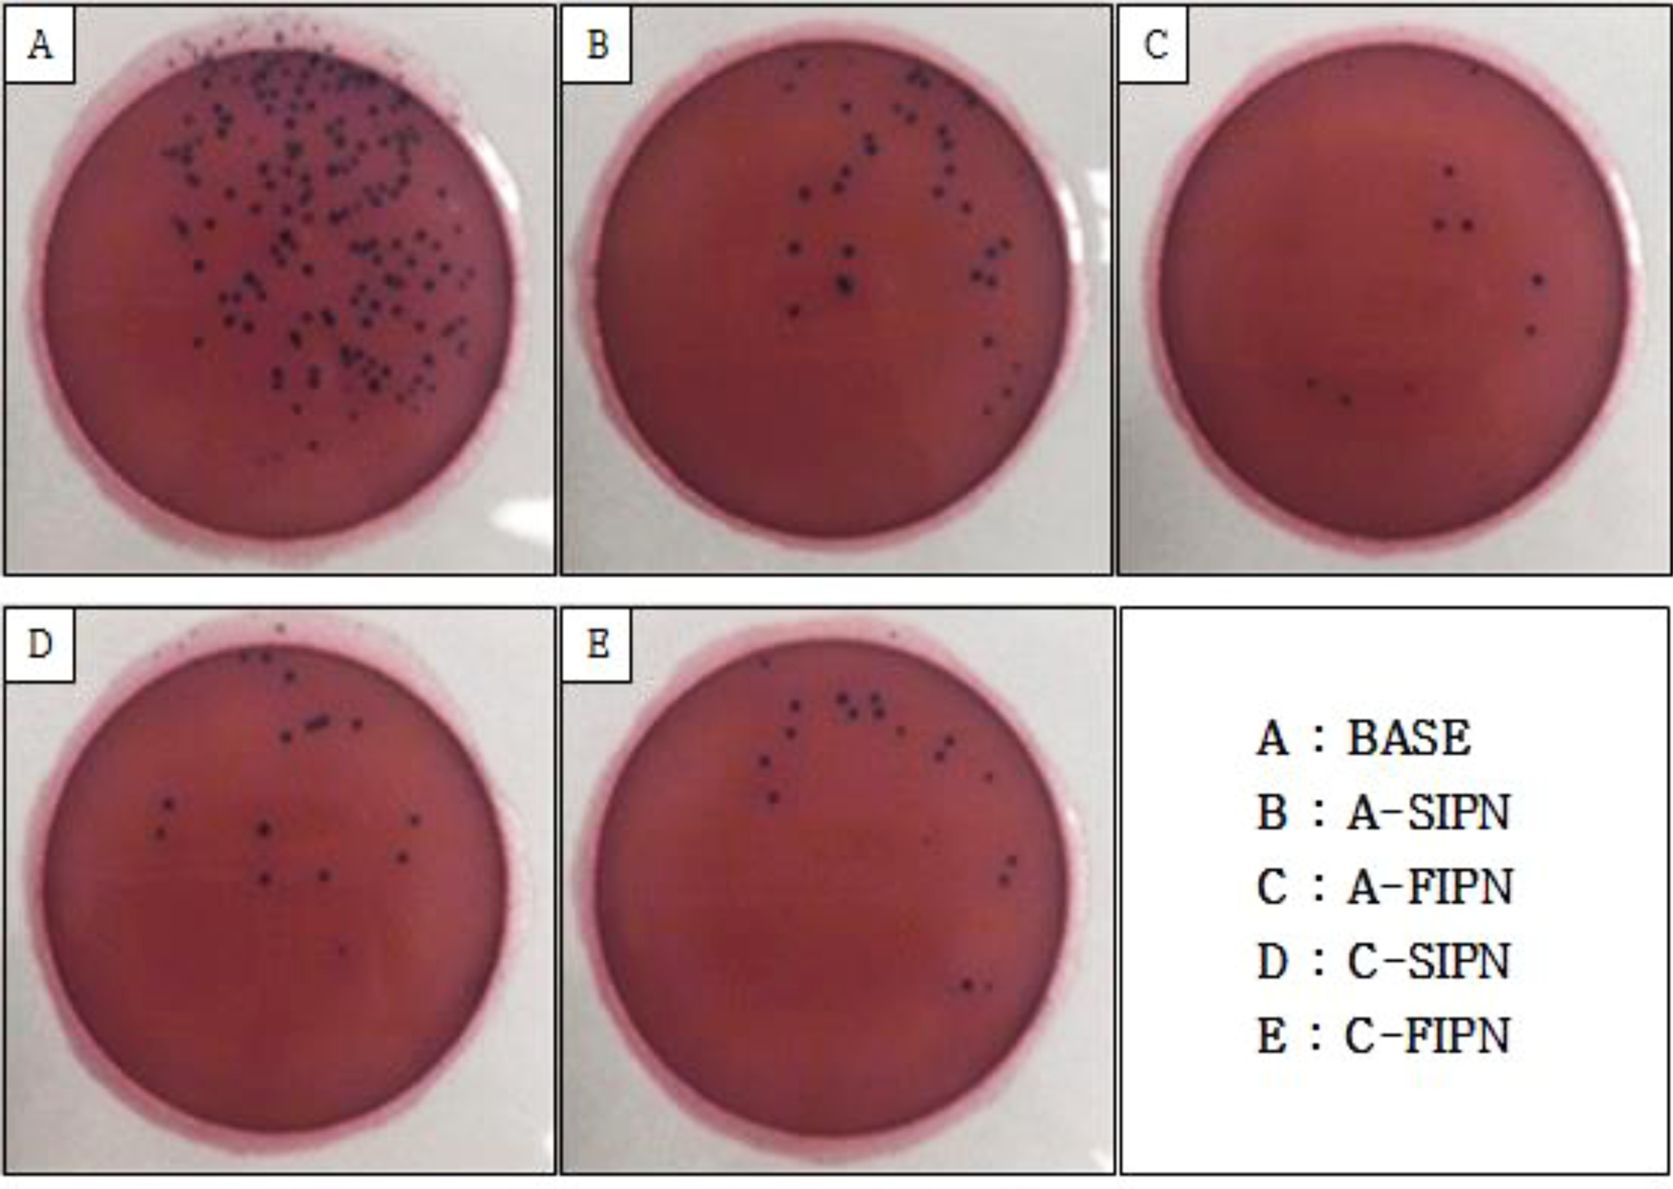

- Study on Characteristic Changes of Contact Lenses According to Interpenetrating Polymer Network Time and Method Using Seaweed Polysaccharide
Na-Young Ko, Pil Heon Lee, A-Young Sung†
 , and Hyun Mee Lee†
, and Hyun Mee Lee† 
Department of Optometry & Vision Science, College of Bio and Medical Science, Daegu Catholic University Hayang-Ro 13-13, Gyeongsan, Gyeongbuk 38430, Korea
- 해조다당류를 이용한 상호침투 고분자 네트워크의 시간과 방법에 따른 콘택트렌즈의 특성변화 연구
대구가톨릭대학교 안경광학과
Reproduction, stored in a retrieval system, or transmitted in any form of any part of this publication is permitted only by written permission from the Polymer Society of Korea.
We investigated the change in the characteristics of contact lenses according to the interpenetrating polymer network (IPN) time and method when a contact lens was dual-networked with alginate and carrageenan. The IPN was formed for four weeks using semi-IPN and full-IPN. The functions of contact lenses were assessed based on the measurement of water content, oxygen permeability, contact angle, protein adsorption, and antimicrobial. With the increase in IPN time, all physical and chemical properties of contact lenses were improved. The oxygen permeability and wettability were better when using alginate than using carrageenan. The water content and oxygen permeability were better when using the semi-IPN method than using the full-IPN method, whereas wettability was further improved when using the full-IPN method. The result of this study verified that seaweed polysaccharides were helpful in the functional improvement of hydrogel contact lenses, and performance was better in a longer IPN time.
본 연구는 하이드로겔 콘택트렌즈에 알지네이트와 카라기난과 같은 해조다당류를 상호침투 고분자 네트워크를 진행하여 interpenetrating polymer network(IPN) 시간에 따른 콘택트렌즈의 특성 변화를 살펴보았다. IPN은 알지네이트와 카라기난을 이용하여 semi-IPN과 full-IPN으로 4주 동안 진행하였다. 콘택트렌즈의 기능은 함수율, 산소투과율, 접촉각, 단백질 흡착, 그리고 항균성 등을 측정하여 평가하였다. IPN 시간이 증가함에 따라 콘택트렌즈의 모든 물리·화학적 성질이 향상되었다. 산소과율과 습윤성은 카라기난보다 알지네이트를 사용했을 때가 더 높았다. 함수율과 산소투과율은 semi-IPN 방법이 full-IPN 방법보다 좋았으며 습윤성은 full-IPN 방법이 더 많이 향상되었다. 해조다당류는 하이드로겔 콘택트렌즈의 기능 향상에 도움이 되며 IPN 시간이 길수록 성능이 더욱 증가함을 확인하였다.
When comparing the contact angles of the contact lenses networked with alginate and carrageenan during the same period, the contact angle of the contact lenses containing alginate was lower than that of carrageenan, resulting in better wettability.

Keywords: contact lens, alginate, carrageenan, interpenetrating polymer network, polysaccharide.
This research was supported by the National Research Foundation of Korea (NRF) grant funded by the Korea government (No. 2018R1A2B6008622)
A hydrogel is a network of cross-linked polymer chains that has the ability to absorb a large quantity of water without being dissolved in the water. Hydrogel has been widely applied in bio-medicine fields such as soft contact lenses, wound dressing, and drug delivery since it has a high water content and biocompatibility.1,2 A hydrogel contact lens affects a cornea significantly as it is placed inside the eye and plays an important role in eye health. Methacrylic acid, which is the main ingredient of hydrogel contact lenses, plays a role in maintaining moisture in the lens and delivering oxygen to the cornea.3,4 However, the amount of oxygen that is delivered to the cornea that passes through the lens is small because oxygen is dissolved by tears in the contact lens. Hypoxia induces hypercapnia and may reduce the corneal function as it causes a change in the physiological process of the corneal tissue.5 To overcome the limitation of hydrogel, hydrophobic silicone polymer has been used to dramatically improve oxygen permeability. However, studies have reported that the wearing comfort has been degraded due to the reduction in wettability and increased fat deposition as a result of the hydrophobic surface and high modulus value compared to those of hydrogel contact lenses.6,7 Although silicone hydrogel lenses have been treated with plasma or hydrophilic materials have been added to the inside of the lens to overcome the limitations of hydrogel and silicone hydrogel, the issues of wettability and wearing comfort remain unresolved.6
In addition, various methods such as the modification of the hydrogel surface or the whole microstructure have been studied to improve the functionality of contact lenses. An interpenetrating polymer network (IPN) is a cross-linked polymer blend, in which other polymers are additionally networked to the original polymer hydrogel. IPN has the advantages of a synergy effect of the ingredients, improvements in mechanical property, and an increase in biostability.8,9 IPN methods are classified as semi-IPN and full-IPN according to whether or not cross-linking agents are added in the IPN process.10,11
Natural polysaccharides are convenient in hydrogel production, have relatively little toxicity, and show biocompatibility compared to synthetic polymers.12 Some of the typical polysaccharides as functional materials that are induced from seaweeds are alginate, carrageenan, fucoidan, and agar. Seaweed polysaccharides have been known to have various bioactive functions such as antioxidant, antitumor, antiviral, and antibacterial effects and for strengthening immunity. They are also used as various raw materials in food, cosmetics, medicine, and seaweed industries.13,14 Among seaweed polysaccharides, alginate is a natural polysaccharide obtained from sargassum fluitans such as seaweed and kelp, which consist of the combination of (1-4)-linked β-D-mannuronate (M) and C-5 epimer α-L-guluronate (G) (Figure 1). Alginate has high wettability that is capable of absorbing moisture of more than 200 to 300 times its own weight, and has been used in a wide range of medical application fields including drug delivery and tissue engineering due to its biocompatibility.15 It is also characterized by a significant increase in elasticity if alginate is cross-linked with calcium ion, which is a divalent metal cation, resulting in an egg-box structure. Alginate has high biocompatibility with high wettability, and is sufficient to be used as a wound dressing to prevent damage to epithelial cells and granulation tissues.16
Carrageenan is a polysaccharide that is extracted from red edible seaweeds (Figure 1). It is one of the prominent biopolymers because it forms a water-soluble gel, is biocompatible, and has potential pharmaceutical properties including anticoagulant, anticancer, and immunoregulatory properties.17 Carrageenan has various molecular structures including kappa(κ)-carrageenan, iota(ι)-carrageenan, and lambda(λ)-carrageenan. Their primary differences depend on the number and position of the ester sulfate groups on the repeating galactose units. Among them, κ-Carrageenan has the most excellent gel formation ability and hysteresis effects as it is a polyelectrolyte with a whole negative charge.18
Such natural polymers are not well mixed with other monomers and cause phase separation, which displays limitations in their reactivity and processability.19 IPN has been used as one of the methods to solve the problem.
A number of studies on hydrogel using seaweed polysaccharides have been conducted and a few have been performed on contact lenses using alginate. However, no studies have been conducted on contact lenses using carrageenan. Thus, the objective of this study was to improve the contact lens functionality with IPN using alginate and carrageenan, which are seaweed polysaccharides among natural polysaccharides. This study also aimed to determine the changes in the physical characteristics of contact lenses according to the types of seaweed polysaccharides, IPN time, and IPN type.

|
Figure 1 Chemical structure of seaweed polysaccharide: (a) alginate; (b) κ-carrageenan |
Reagent and Specimen Fabrication. Products procured from Sigma-Aldrich were used as the main ingredients of hydrogel contact lenses. The main ingredients comprised 2-hydroxyethylmethacrylate (HEMA), 2-methacryloyloxyethyl phosphorylcholine (MPC), and N-vinyl-2-pyrrolidone (NVP). In addition, ethylenglycoldimethacrylate (EGDMA) was used as the cross-linking agent and a product from Junsei Chemical Co., Ltd. was used as the initiator 2,2-azobis(isobutyronitrile) (AIBN). Alginate and κ-carrageenan, which are seaweed polysaccharides, N,N’-methylenebisacrylamide (MBAA), which is a cross-linking agent used in the IPN, and ammonium persulfate (APS), which is an initiator, were additional products that were procured from Sigma-Aldrich.
Contact lenses were manufactured in two steps. In the first step, hydrophilic monomers HEMA, MPC, and NVP were mixed with AIBN as an initiator, and EGDMA as a crosslinking agent, followed by thermal polymerization at 100 °C for 1 h using a casting mold method. The second step is IPN inside the contact lens using polysaccharides. For semi-IPN, the lenses manufactured in the first step were immersed by mixing APS in 1% alginate or 1% κ-carrageenan solution, respectively. Full-IPN manufactured contact lenses using a solution of APS/MBAA instead of APS in the semi-IPN process. The IPN process was carried out for 1, 3, 7, 14, and 28 days, and after the reaction was completed, the unreacted material was removed and the physical properties were evaluated. Schematic diagrams of semi-IPN and full-IPN methods (Figure 2).
The naming of the specimens was as follows. The basic specimen was named “BASE.” A specimen was named “A” when alginate was the IPN material, “C” when the IPN material was carrageenan. Semi-IPN was named SIPN, and full-IPN was named FIPN according to the IPN method used (Table 1).
Measurement of Physical Characteristics. The light transmittance was measured using the cary 60 UV spectrophotometer by performing semi-IPN and full-IPN with alginate and carrageenan on a contact lens for 28 days.
The water content, contact angle, and oxygen permeability for each of the fabricated specimens were measured, and a mean value of five measurements per specimen for each measurement item was used.
For the water content, a weight measurement method specified in ISO 18369-4:2006 was used, and the following eq. was used to calculate the water content.

EWC refers to a water content at the equilibrium state, Wswell refers to a specimen weight immersed in a phosphate buffered saline (PBS) solution for 24 h, and Wdry refers to a specimen weight dried in an oven for 16 h. For contact angle measurements, specimens hydrated for 24 h using DSA30 of GMBH were measured via the sessile drop method. The oxygen permeability (Dk/t) was measured based on the ISO 18369-4:2006 standard, and the 201T Permeometer of the Rehder Development Company was used via the polarographic method. The radius of curvature of the used polarographic cell was 8.7 mm, and a temperature was maintained at 35±0.5 ℃.
Protein Quantification. For proteins, bovine serum albumin (BSA), which is similar to the form and chemical properties of human albumin, was used in the experiment, and the product of Sigma-Aldrich was employed. The PBS solution containing 5 mg/mL BSA was fabricated and 2 mL of the solution was put into a vial. Then, each of the specimens was put into the BSA solution and incubated for 24 h at 37 oC to adsorb the protein. Each of the specimens adsorbed with protein was cleansed twice with PBS and then put into a sodium dodecyl sulfate (SDS) solution (3%) dissolved in dd-H2O. Then, each specimen was heated in an oven at 95 oC for 15 min and the protein attached to the specimen was desorbed by shaking the specimen slowly for three min in a vortex. The Agilent Cary 60 UV-Vis Spectrophotometer was used to measure the absorbance, and the absorbance value was checked at 280 nm, which was the maximum absorption wavelength of proteins. The molar absorptivity (ε) was 3.35 mg·cm/g, and the protein concentration was calculated using the eq. A=εbC. The protein adsorption was calculated using the following eq.20

Q refers to the protein adsorption, V refers to the solution amount, C refers to the protein concentration, and m refers to the hydrated specimen weight.
Antimicrobial. The antimicrobial evaluation was conducted using the basic specimen BASE and 28 day IPN specimens using seaweed polysaccharide. The bacteria used to determine the antimicrobial was Escherichia coli (E. coli, ATCC 10536), and the bacterial strain was distributed from the Korea Culture Center of Microorganisms. The broth used in the antimicrobial experiment was mixed with 2 g peptone and 1.2 g beef in 40 mL distilled water and set to pH 7.0, and then sterilized in an autoclave. The E. coli was free-cultured in the broth before it was used in the experiment. Each specimen was put into a vial containing the broth, which was then cultured at 35 oC for 12 h after inserting 1 mL of the E. coli followed by diluting the broth 1,000 times. 1 mL of the diluted solution was smeared on a Petrifilm plate and incubated at 35 oC for 24 h. For the dehydrated medium, the E. coli 3 M PetrifilmTM Count Plate was used.

|
Figure 2 Formation and structure of semi- and full interpenetrating polymer networks (IPN). |
|
Table 1 Composition of Hydrogel Contact Lens and Nomenclatures of Samples (unit: wt%) |

Assessment of Physical Characteristics. Transmittance and Water Content: The contact lenses networked with alginate and carrageenan showed a decrease in transmittance compared to the basic lens. The transmittance of the alginate-networked lens changed little over time, but the transparency of the lens using carrageenan decreased sharply after 7 days (Figure 3).
The water content is one of the important properties that determine the comfort and fitting characteristics of contact lenses, and significantly affects the properties of contact lenses including oxygen permeability.21,22 The water content of BASE, which was the specimen before IPN formation, and water contents of the specimens were measured according to IPN method and time, and types of seaweed polysaccharides. Figure 4 shows the results of the water contents. The water content of the specimen BASE prior to IPN formation using alginate and κ-carrageenan, which are seaweed polysaccharides, was 56.7%. This value was reported generally higher than that of the HEMA lens, which was around 38%, by adding MPC and NVP, which are hydrophilic substances. The water content of the basic specimen BASE was compared with that of IPN contact lenses using alginate and κ-carrageenan, and the results are as follows.
In the 1-day IPN results, the water content of the semi-IPN specimen using alginate (A-SIPN) was the highest at 58.8%, which was increased by around 3.6% compared with that of BASE without IPN. In the 28 day IPN results, the water content of the semi-IPN specimen using carrageenan (C-SIPN) was the highest at 61.7%, which was increased by around 8.1% compared with that of BASE. Although the water content of both alginate and κ-carrageenan tended to increase with the IPN time, the increase was small. The comparison results of the water contents between the semi-IPN and the full-IPN for the same period of time showed that the water contents of the semi-IPN specimen using both alginate and κ-carrageenan were slightly higher than those of the full-IPN specimens. The study by Lee et al.23 also reported that the swelling ratio of the semi-IPN specimen was higher than that of the full-IPN specimen. This finding resulted from the reduction in water content in the full-IPN, which had a greater increase in the cross-linking degree and a denser network formation.24 In addition, no significant difference was found between the IPN specimens for the same period of time using alginate and κ-carrageenan.
Oxygen Permeability. Since the cornea contains no blood vessels, oxygen to the cornea must be supplied from the air. Thus, oxygen should be supplied properly through contact lenses from the air during wear. If oxygen is not delivered to the cornea sufficiently, side effects such as corneal hypoxia, corneal neovascularization, and endothelial cell polymorphism may occur.25,26 Thus, oxygen permeability (Dk/t), which expresses the oxygen amount delivered through contact lenses, is one of the important physical properties for the metabolism of the cornea. The unit of oxygen permeability is 10-9 (cm/sec)(mLO2/mL×mmHg).
Figure 5 shows the results of oxygen permeability of contact lenses with IPN formation using seaweed polysaccharides. The oxygen permeability of BASE without IPN was 22.89×10-9. The results according to the IPN time showed that the oxygen permeability was gradually increased in both the semi-IPN and full-IPN specimens using alginate as the IPN time increased. On the other hand, no significant changes in oxygen permeability of the semi-IPN and full-IPN specimens using κ-carrageenan were found and after 14 days, oxygen permeability was slightly increased.
The comparison results of oxygen permeability between semi-IPN and full-IPN specimens for the same period of time showed that all cases using alginate exhibited slightly higher oxygen permeability in semi-IPN specimens than in full-IPN specimens. No difference in oxygen permeability was found until IPN 7 days in the case of κ-carrageenan. However, after IPN 14 days, oxygen permeability was higher in the semi-IPN specimen than in the full-IPN specimen. The comparison results of oxygen permeability between IPN specimens using alginate and κ-carrageenan for the same period of time revealed that both the semi-IPN and full-IPN specimens had higher oxygen permeability when using alginate. Among them, the semi-IPN specimen using alginate (A-SIPN) for 28 days exhibited the highest oxygen permeability at 25.84×10-9. This result was increased by around 11.4% than that of BASE without IPN. Oxygen permeability has been known to be affected by water content, resulting in an increase in water content along with an increase in oxygen permeability.21,27 The water content tended to slightly increase with the increase in IPN time when adding seaweed polysaccharides. As a result, the change in oxygen permeability tended to increase with the increase in IPN time.
Wettability. Wettability is one of the foremost properties in maintaining a tear film and the physiological adaptation of the eye as it determines the wetting aspect of tears on the surface of contact lenses.28 Wettability is calculated by a contact angle that displays the degree of dispersion of liquid on the solid surface. The higher the wettability is the lower the contact angle.
The results of the contact angle of each specimen in this study are shown in Figure 6. The contact angle of BASE without IPN was 38.7 oC, and the contact angles of all specimens were gradually decreased as the IPN time increased. The contact angles of A-SIPN and A-FIPN, which were IPN specimens using alginate, were gradually decreased with the IPN time. Figure 6(b) shows the contact angle of A-SIPN and A-FIPN, which are IPN contact lenses using alginate for 7 days. In particular, the contact angles of A-SIPN and A-FIPN for 14 day IPN were reduced by 29.2 and 37.2%, respectively, compared with that of BASE, which showed a clear difference. However, no significant changes in the contact angles of A-SIPN and A-FIPN for 28 day IPN were found. The contact angles of C-SIPN and C-FIPN using κ-carrageenan were also gradually decreased with the IPN time. The contact angles of C-SIPN and C-FIPN for 7 day IPN using κ-carrageenan were reduced by 18.9 and 29.7%, respectively, compared with that of BASE, which showed a significant decrease. However, the reduction rates of the contact angles of C-SIPN and C-FIPN for 14 and 28 day IPN were lower than those of IPN specimens for 7 day IPN.
The wettability was decreased with the increase in IPN time in seaweed polysaccharides, which were penetrated into the network gradually rather than in a short period of time. The comparison results of the contact angle between the semi-IPN and full-IPN for the same period of time showed that the contact angles using the full-IPN method in both alginate and κ-carrageenan were lower than those using the semi-IPN method. For alginate, the difference rate in contact angles due to the IPN method was highest in the 28 day IPN specimen at 12.5%. For κ-carrageenan, the difference rate due to the IPN method was highest in the 7 day IPN specimen at 13.4%. The comparison results of the contact angles between the alginate and carrageenan IPN specimens for the same period of time showed that the contact angle of alginate was generally lower than that of κ-carrageenan. Among the results, the contact angle of A-FIPN was the lowest at 23.8°, which was decreased by about 38.5% compared with that of BASE. When comparing the semi-IPN and full-IPN, the overall wettability of the full-IPN was higher than that of the semi-IPN. The better wettability of the full-IPN was attributed to the full-IPN using a cross-linking agent, which reacted more strongly between the polymers where a network was formed. This resulted in increased penetration of seaweed polysaccharides that created a lubricating layer on the surface of the contact lens.
Protein Adsorption. When proteins are deposited in soft contact lenses, side effects that can cause eye diseases such as decreased wear comfort, decreased vision, dry eyes, and giant papillary conjunctivitis occur.29,30 The molecular weight of lysozyme, which was one of the ingredients found in tears, is very small at 14.3 kDa. The positive charge and small size of lysozyme attract negative charges so that a large amount of lysozyme is deposited in hydrogel contact lenses. In contrast, the molecular weight of albumin is as large as 66.4 kDa, and albumin is negatively charged compared with tears in a relative sense. Smith et al.31 reported that protein adsorption was affected by the water content, and the amount of deposited proteins and type of proteins differed with the increase in water content according to the ionic properties of the protein. In general, contact lenses with low water content have a larger deposit amount of albumin whereas contact lenses with high water content have a larger deposit amount of lysozyme.
This study measured protein adsorption using the BSA in contact lenses with high water content, and the values are shown in Figure 7. The protein adsorption of the basic BASE specimen was the highest at 6.824 mg/g. The results according to the IPN time showed that the protein adsorptions using both alginate and κ-carrageenan were gradually decreased as the IPN time increased. This result was obtained because alginate and κ-carrageenan are anionic materials. This results in a charge repulsion against the BSA, which is negatively charged thereby reducing the protein adhesion.32 Thus, the seaweed polysaccharides slowly penetrated the contact lenses as the IPN time increased. The comparison results of protein adsorption between the semi-IPN and full-IPN specimens for the same period of time showed that cases using alginate generally exhibited lower protein adsorption in full-IPN specimens than in semi-IPN specimens. The protein adsorptions of all full-IPN specimens were lower than those of semi-IPN specimens except for the IPN 7 day and IPN 14 day specimens in the case of κ-carrageenan. However, no significant difference in protein adsorption was found in the semi-IPN and full-IPN specimens using both alginate and κ-carrageenan. In addition, when comparing the protein adsorption between IPN specimens for the same period of time using alginate and κ-carrageenan, the protein adsorption of alginate was lower than that of κ-carrageenan. Protein adsorption is significantly affected not only by water content but also by wettability.33 With higher surface wettability, the adsorption of precipitates such as proteins can be reduced.34 Accordingly, the reason for the lower protein adsorption in alginate was because the higher wettability of alginate than that of κ-carrageenan seemed to affect protein adsorption.
Antimicrobial. Surface bacterial contamination, which induces biomembrane formation, has been a major problem in various fields such as pharmaceutical products. Once a biomembrane is formed on the surface of contact lenses, it may induce corneitis and conjunctivitis, or permanent vision loss at worst. As antimicrobial materials inhibit such biomembrane formation, much attention has been paid to natural polysaccharides as a prominent material.35
This study examined the antimicrobial according to the IPN methods used and cross-linked the specimens with seaweed polysaccharides. Compared to the BASE specimen without cross-linking seaweed polysaccharides, antimicrobial activities were increased by adding seaweed polysaccharides. Many of the natural polysaccharides have been known to have antibiotic properties, and alginate, which is one of the seaweed polysaccharides, has been proven to have antimicrobial activities.13,14 The contact lens cross-linked with seaweed polysaccharide showed a very low number of colonies compared to 427 CFU/mL of the BASE lens, indicating excellent antibacterial properties. Contact lenses with full-IPN using alginate showed a value of 9 CFU/mL and showed the best antibacterial properties. Figure 8

|
Figure 3 Transmittance of according to IPN time of contact lens using seaweed polysaccharides. |

|
Figure 4 Water content of hydrogel contact lens with seaweed polysaccharides. |

|
Figure 5 Oxygen permeability of contact lens according to IPN time. |

|
Figure 6 Contact angle of contact lens: (a) contact angle according to IPN time; (b) contact angle of IPN contact lenses for 7 days using alginate; BASE(top), A-SIPN(middle) and A-FIPN(bottom |

|
Figure 7 Protein adsorption of contact lens according to IPN time. |
|
Figure 8 Antimicrobial activity of contact lens with seaweed polysaccharide for E. coli. |
This study evaluated the physical characteristics of contact lenses by adding seaweed polysaccharides to hydrogel contact lenses and investigated changes in the physical properties according to the IPN time. For seaweed polysaccharides, alginate and carrageenan were used for comparison, and IPN specimens were divided into semi-IPN and full-IPN specimens for comparison. When comparing alginate and carrageenan, no significant changes in water content and oxygen permeability were found. However, the wettability of alginate was higher than that of carrageenan while the protein adsorption was lower than that of carrageenan. With the increase in IPN time, all of the properties, including water content, oxygen permeability, and wettability tended to improve while the protein adsorption was decreased. In addition, the physical properties of full-IPN specimens were further improved than those of semi-IPN specimens. This study verified that adding seaweed polysaccharides to contact lenses improved the preferable functions of contact lenses. In particular, seaweed polysaccharides will be utilized as materials to improve wettability and antimicrobial functions of contact lenses.
- 1. Omidian, H.; Rocca, J. G.; Park, K. Advances in Superporous Hydrogels. J. Control. Release 2005, 102, 3-12.
-

- 2. Sirkecioglu, A; Mutlu, H. B.; Citak, C.; Citak, C.; Güner, F. S. Physical and Surface Properties of Polyurethane Hydrogels in Relation with Their Chemical Structure. Polym. Eng. Sci. 2014, 54, 1182-1191.
-

- 3. Garrett, Q.; Laycock, B.; Garrett, R. W. Hydrogel Lens Monomer Constituents Modulate Protein Sorption. Investig. Ophthalmol. Vis. Sci. 2000, 41, 1687-1695.
- 4. Refojo M. F. Water Imbibition. In Contact Lenses: The CLAO Guide to Basic Science and Clinical Practice; Dabezies, O.H., Ed.; Grune and Stratton: New York, 1991, pp 1-4.
- 5. Nichols, J. J.; Ziegler, C.; Mitchell, G. L.; Nichols, K. K. Self-Reported Dry Eye Disease across Refractive Modalities. Investig. Ophthalmol. Vis. Sci. 2005,46, 1911-1914.
-

- 6. Carney, F. P.; Nash, W. L.; Sentell, K. B. The Adsorption of Major Tear Film Lipids in Vitro to Various Silicone Hydrogels Over Time. Investig. Ophthalmol. Vis. Sci. 2008, 49, 120-124.
-

- 7. Maldonado-Codina, C.; Efron, N. Impact of Manufacturing Technology and Material Composition on The Clinical Performance of Hydrogel Lenses.Optom. Vis. Sci. 2004, 81, 442-454.
-

- 8. Han, Y. A.; Lee, E. M.; Ji, B. C. Mechanical Properties of Semi-interpenetrating Polymer Network Hydrogels based on Poly(2-hydroxyethyl methacrylate) Copolymer and Chitosan.Fibers Polym. 2008, 9, 393-399.
-

- 9. Sperling, L. H.; Hu, R. Interpenetrating Polymer Networks. In Polymer Blends Handbook; Utracki, L. A., Ed.; Springer: Dordrecht, 2003, pp 417-447.
- 10. Matricardi, P.; Di Meo, C.; Coviello, T.; Hennink, W. E.; Alhaique, F. Interpenetrating Polymer Networks Polysaccharide Hydrogels for Drug Delivery and Tissue Engineering.Adv. Drug. Deliv. Rev. 2013, 65, 1172-1187.
-

- 11. Sperling, L. H.; Mishra, V. The Current Status of Interpenetrating Polymer Networks. Polym. Advan. Techol. 1996, 7, 197-208.
-

- 12. Thambi, T.; Phan, V. H.; Lee, D. S. Stimuli‐Sensitive Injectable Hydrogels Based on Polysaccharides and Their Biomedical Applications. Macromol. Rapid Commun. 2016, 37, 1881-1896.
-

- 13. Silva, S. S.; Gomes, J. M.; Rodringues, L. C.; Reis, R. L. Marine-Derived Polymers in Ionic Liquids: Architectures Development and Biomedical Applications. Mar. Drugs 2020, 18, 346-375.
-

- 14. Molinski, T. F.; Dalisay, D. S.; Lievens, S. L.; Saludes, J. P. Drug Development from Marine Natural Products. Nat. Rev. Drug. Discov. 2009, 8, 69-85.
- 15. Sahoo, D. R.; Biswal, T. Alginate and its Application to Tissue Engineering. SN Appl. Sci. 2021, 3, 1-19.
-

- 16. Puscaselu, R. G.; Lobiue, A.; Dimian, M.; Covasa, M. Alginate: from Food Industry to Biomedical Applications and Management of Metabolic Disorders. Polymers 2020, 12, 2417-2447.
-

- 17. Khotimchenko, Tiasto, M.; Kalitnik, V. A.; Begun, M.; Khotimchenko, R.; Leonteva, E.; Bryukhovetskiy, I.; Khotimochenko, Y. Antitumor Potential of Carrageenans from Marine Red Algae. Carbohydr. Polym. 2020, 246, 116568-116584.
-

- 18. Shchipunov, Y. A. Structure of Polyelectrolyte Complexes by the Example of Chitosan Hydrogels with lambda-carrageenan. Polym. Sci., Ser. A 2020, 62, 54-61.
-

- 19. Kim, S. J.; Park, S. J.; Kim, S. I. Swelling Behavior of Interpenetrating Polymer Network Hydrogels Composed of Poly(vinyl alcohol) and Chitosan. React. Funct. Polym. 2003, 55, 53-59.
-

- 20. Seredych, M.; Mikhalovska, L.; Mikalovsky, S.; Gogotsi, Y. Adsorption of Bovine Serum Albumin on Carbon-Based Materials. C-J Carbon Res. 2018, 4, 3-16.
-

- 21. Efron, N.; Morgan, P.; Camerron, Lan, D. Oxygen Permeability and Water Content of Silicone Hydrogel Contact Lens Materials. Optom. Vis. Sci. 2007, 84, 328-337.
-

- 22. Tran, N.-P.-D.; Ting, C.-C.; Lin, C.-H.; Yang, M.-C. A Novel Approach to Increase the Oxygen Permeability of Soft Contact Lenses by Incorporating Silica Sol. Polymers 2020, 12, 2087-2099.
-

- 23. Lee, S. B.; Park, E. K.; Lim, Y. M.; Cho, S. K.; Kim, S. Y.; Lee, Y. M.; Nho, Y. C. Preparation of Alginate/poly(N-isopropylacryl- amide) Semi-interpenetrating and Fully Interpenetrating Polymer Network Hydrogels with γ-ray Irradiation and Their Swelling Behaviors.J. Appl. Polym. Sci. 2006, 100, 4439-4446.
-

- 24. Hu, X.; Lu, L.; Xu, C.; Li, X. Mechanically Tough Biomacro- molecular IPN Hydrogel Fibers by Enzymatic and Ionic Crosslinking. Int. J. Biol. Macromol. 2015,72, 403-409.
-

- 25. Hoffman, A. S. Hydrogels for Biomedical Applications. Adv. Drug Deliv. Rev. 2002,54, 3-12.
-

- 26. Fonn, D.; Bruce, A. S. A Review of the Holden-Mertz Criteria for Critical Oxygen Transmission. Eye Contact Lens 2005,31, 247-251.
-

- 27. Tran, N.-P.-D.; Ting, C.-C.; Lin, C.-H.; Yang, M.-C. A Novel Approach to Increase the Oxygen Permeability of Soft Contact Lenses by Incorporating Silica Sol. Polymers 2020, 12, 2087-2097.
-

- 28. Tranoudis, I.; Efron, N. Parameter Stability of Soft Contact Lenses Made from Different Materials. Cont. Lens Anterior Eye 2004,27, 115-131.
-

- 29. Luensmann, D.; Jones, L.Albumin Adsorption to Contact Lens Materials: a Review.Cont. Lens Anterior Eye 2008,31, 179-187.
-

- 30. Nicolson, P. C.; Vogt, J. Soft Contact Lens Polymers: an Evolution.Biomaterials 2001,22, 3273-3283.
-

- 31. Allansmith, M. R.; Korb, D. R.; Greiner, J. V.; Henriquez, A. S.; Simon, M. A.; Finnemore, V. M. Giant Papillary Conjunctivitis in Contact Lens Wearers. Am. J. Ophthalmol. 1997, 83, 697-708.
-

- 32. Noh, H.; Vogler, E. A. Volumetric Interpretation of Protein Adsorption: Competition from Mixtures and the Vroman Effect. Biomaterials 2007, 28, 405-422.
-

- 33. Prime, K. L.; Whitesides, G. M. Self-assembled Organic Monolayers: Model Systems for Studying Adsorption of Proteins at Surfaces. Science 1991, 252, 1164-1167.
- 34. Hohn, S.; Virtanen, S.; Boccaccini, A. Protein Adsorption on Magnesium and Its alloys: A Review. Appl. Surf. Sci. 2019,464, 212-219.
-

- 35. Laurienzo, P. Marine Polysaccharides in Pharmaceutical Applications: An Overview. Mar. Drugs 2010, 8, 2435-2465.
-

- Polymer(Korea) 폴리머
- Frequency : Bimonthly(odd)
ISSN 0379-153X(Print)
ISSN 2234-8077(Online)
Abbr. Polym. Korea - 2025 Impact Factor : 1.0
- Indexed in SCIE
 This Article
This Article
-
2021; 45(5): 775-782
Published online Sep 25, 2021
- 10.7317/pk.2021.45.5.775
- Received on May 25, 2021
- Revised on Jun 17, 2021
- Accepted on Jul 7, 2021
 Services
Services
- Full Text PDF
- Abstract
- ToC
- Acknowledgements
Introduction
Experimental
Results and Discussion
Conclusions
- References
Shared
 Correspondence to
Correspondence to
- A-Young Sung and Hyun Mee Lee
-
Department of Optometry & Vision Science, College of Bio and Medical Science, Daegu Catholic University Hayang-Ro 13-13, Gyeongsan, Gyeongbuk 38430, Korea
- E-mail: sayy@cu.ac.kr, hmlee@cu.ac.kr
- ORCID:
0000-0002-9441-919X, 0000-0001-6668-5864








 Copyright(c) The Polymer Society of Korea. All right reserved.
Copyright(c) The Polymer Society of Korea. All right reserved.